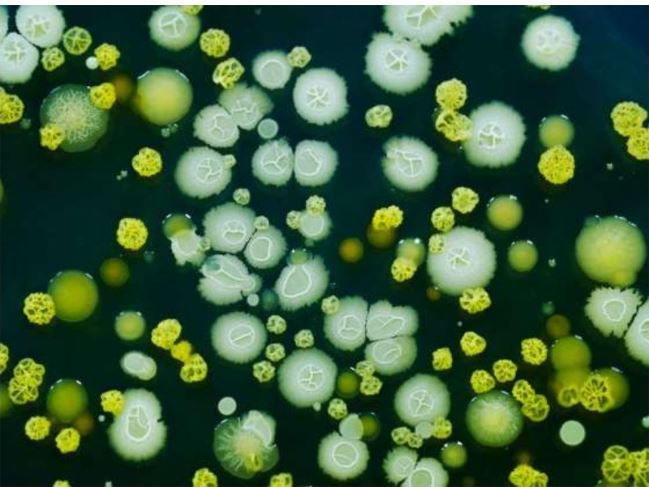

Много лет люди ищут секрет бессмертия, а между тем, на нашей планете уже живут существа, которые в той или иной мере бессмертны. Интересно, что все они живут в океане. Может быть это не случайно?
МЕДУЗА ОБРАТНОГО СТАРЕНИЯ

Эта крошечная разновидность медуз, называется Turritopsis doohmii, или бессмертная медуза. Исследования показали, что она нашла способ обмануть смерть, просто изменив процесс старения. Если с ней что-то случается, например, болезнь, травма, она возвращается в стадию полипа, и соответственно ее клетки возвращаются в молодое состояние и жизнь начинается сначала.
КРЕПКИЕ ЧЕРЕПАХИ

Чем медленнее животное, тем быстрее оно выигрывает гонку за жизнь. Как известно, черепахи живут веками, а их органы практически не стареют. Так что черепахи могут жить вечно, если не подвергнутся физическому воздействию с чьей-то стороны.
РАДИАЦИОННО УСТОЙЧИВАЯ БАКТЕРИЯ
Это бактерия Deinococcus radiodurans. Причем она не только устойчива к радиации, она может даже умереть, но ее ДНК устроено таким образом, что развивается снова, и она возрождается. Эта бактерия может жить в вакууме, при обезвоживании, при очень низких температурах и даже в кислоте.
В Книге рекордов Гиннесса даже говорится, что они «могут противостоять 1,5 миллиона радов гамма-излучения, что примерно в 3000 раз больше, чем нужно, чтобы убить человека!»
РЕГЕНЕРИРУЮЩИЕ ПЛОСКИЕ ЧЕРВИ

Эти неприятные черви способны к регенерации. Если его разрезать, хоть вдоль, хоть поперек, образуется два червя. Поэтому эти существа могут обмануть смерть на неопределенный срок.
САМЫЙ НЕУНИЧТОЖИМЫЙ ВИД НА ПЛАНЕТЕ

Это тихоходка (tardigrada). Если вы попытаетесь ее убить-у вас это не получится, потому, что это практически бессмертное животное. Эти существа живут тысячилетиями, а если попадают в экстримальные условия, то входят в состояние криптобиоза. Когда наступает благоприятный период-они оживают. Они очень выносливы.
Доказано, что они выдерживают 30-летнее пребывание при температуре 20° ниже нуля.
ГИГАНТСКИЕ КИТЫ

Вообще, эти киты не бессмертны, но в настоящее время гренландский кит остается самым старым живым млекопитающим. Некоторые киты живут более 70 лет.
В 1990-х годах ученые обнаружили на массивных животных рубцы, сделанные оружием 1800-х годов. Самый старый из известных гренландских китов дожил до 211 лет.
Всем известно, что киты очень умные существа.
ВЕЧНО РАСТУЩИЕ ОМАРЫ

Эти животные умирают, но от болезни, а не от старости. К тому же омары до самой смерти растут и размножаются.
Согласно оценкам ученых, одному лобстеру, пойманному у побережья Ньюфаундленда, было 140 лет.
Эти особи не относятся к бессмертным, но особи женского пола живут до 54 лет, а мужского до 30 лет, и чем они больше-тем старше.
Интересно, а вам хотелось бы стать бессмертными?












